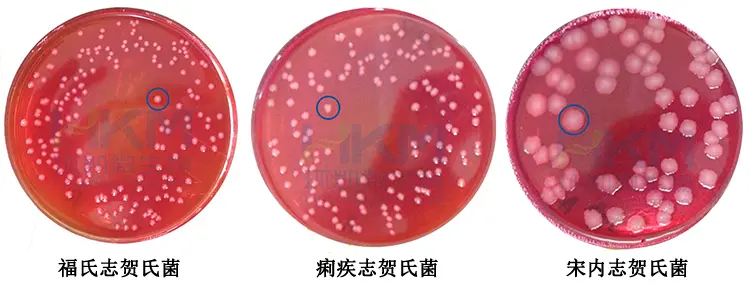

食品微生物检验志贺氏菌检验常用培养基原理解析
发布时间:2020-10-15 浏览次数:9384
1. 志贺氏菌增菌肉汤培养基
•培养基中除胰蛋白胨、葡萄糖外,加入新生霉素作抑菌剂,并加入少量的吐温80作增溶剂,以帮助样品的充分分散。
•41℃厌氧培养有助于抑制其它杂菌生长。
2. 麦康凯琼脂培养基(MAC)
•利用胆盐来抑制革兰氏阳性细菌的生长;利用乳糖发酵,中性红的颜色可把分解乳糖和不分解乳糖的细菌区分开。
•志贺氏菌呈无色菌落,半透明,光滑,湿润,圆形,边缘整齐或不齐。

麦康凯琼脂培养(MAC)
•脱氧胆酸钠可以抑制革兰氏阳性细菌和部分大肠杆菌,多数志贺氏菌不能发酵木糖,木糖的添加可将志贺氏菌与其它菌株区别开来,因此,志贺氏菌在XLD平板上呈现无色菌落,但少数发酵木糖的志贺氏菌在此平板上会被漏检,XLD平板对宋内志贺氏菌亦有轻度抑制作用。
•志贺氏菌通常呈粉红色至无色,半透明,光滑,湿润,圆形,边缘整齐或不齐菌落。

木糖-赖氨酸-去氧胆酸盐(XLD)琼脂菌落特征
•利用非志贺氏菌的特异性的酶,使其与酶底物结合形成不同颜色的菌落,而生化特性反应不活跃的志贺氏菌经22~28h培养后,则形成易于识别的白色-粉红色(与培养基颜色相近)的菌落。
•志贺氏菌呈白色/清晰的菌落,大小约为1~3mm,周围培养基变红。
5.三糖铁琼脂培养基
•该培养基含有乳糖、蔗糖和葡萄糖的比例为10:10:1,只能利用葡萄糖的细菌,葡萄糖被分解产酸使斜面先变黄,但因量少,生产的少量酸。因接触空气而氧化,加之细菌生长利用培养基中含氮物质,生成碱性产物,故斜面后来又变红。底部由于厌氧状态,酸类不被氧化,仍保持黄色。而发酵乳糖的细菌,则产生大量的酸,使整个培养基呈黄色。另外,因某些细菌能分解含硫氨基酸,生成硫化氢,硫化氢和培养基中的铁盐反应生成黑色的硫化亚铁沉淀。

三糖铁
6.靛基质试验
•某些细菌能分解蛋白胨中的色氨酸,生成吲哚。吲哚的存在可用显色反应表现出来。吲哚与对二甲基氨基苯醛结合,形成玫瑰吲哚,为红色化合物。
•结果判读:阳性为滴加靛基质试剂后液面立即变玫红色; 阴性为滴加试剂后不变红色。

靛基质试验
7.尿素酶试验
•具有尿素酶的细菌分解培养基中的尿素,产生大量的氨,使培养呈碱性,酚红指示剂在pH6.8时呈黄色,pH8.1呈粉红色。
•结果判读:阳性为玫红色; 阴性为淡橙红色-淡黄色。

尿素酶试验
8.赖氨酸、鸟氨酸脱羧酶试验
•具有氨基酸脱羧酶的细菌,能分解氨基酸使其脱羧生成胺(赖氨酸→尸胺)和二氧化碳,使培养基变碱,使指示剂显示出来。
•结果判读:阳性为试验管为绿色-蓝绿色,对照管变黄色; 阴性为试验管和对照管均变黄色,或均不变色。

赖氨酸脱羧酶试验阳性
9.糖(醇)发酵试验
•绝大多数细菌都能利用糖(醇)类作为碳源和能源,但是它们在分解糖(醇)的能力上有很大的差异,有些细菌能分解某种糖(醇)并产酸(如乳酸、醋酸、丙酸等)和气体(如氢、甲烷、二氧化碳等);有些细菌只产酸不产气。酸的产生可利用指示剂来断定。
•(指示剂为溴甲酚紫)结果判读:阳性为变黄色; 阴性为紫色。

甘露醇发酵试验
10.β-半乳糖苷酶
•某些细菌可产生b-半乳糖苷酶,能分解邻硝基酚-b半乳糖苷(ONPG),生成黄色的邻硝基酚。
•结果判读:阳性为黄色; 阴性为不变色-淡黄色。

ONPG生化管
11. 葡萄糖铵试验
•鉴别细菌利用铵盐作为唯一氮源并分解葡萄糖的试验。溴麝香草酚蓝是指示剂,产酸时培养基由绿色变黄色。
•结果判读:阳性为黄色; 阴性为绿色。

葡糖糖铵利用试验
12. 西蒙氏柠檬酸盐培养基
•细菌能利用柠檬酸盐作为唯一的碳源,能在除柠檬酸盐外不含其他碳源的培养基上生长,分解柠檬酸盐生成碳酸钠,使培养基变碱性。
•结果判读:阳性为蓝绿-蓝色; 阴性为绿色。

西蒙氏柠檬酸盐培养基试验
13. 粘液酸盐试验
•某些细菌能利用粘液酸盐,分解产酸,使培养基中的溴麝香草酚蓝变黄色。
•结果判读:阳性为黄色; 阴性为绿色-蓝绿色。

粘液酸盐试验











